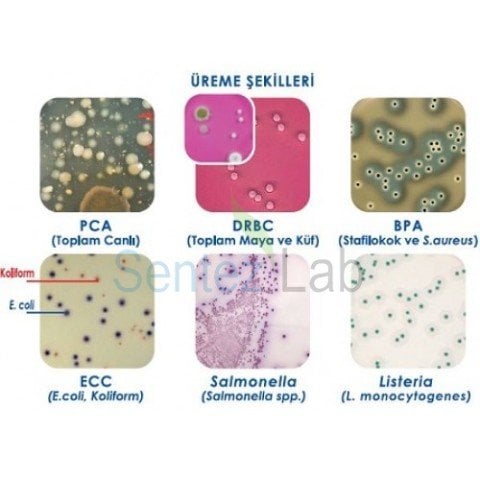
HYTECH SLİDE, E.Coli/Coliform 30 Slide

HYTECH SLİDE, E.Coli/Coliform 30 Slide
0 -
Yorum Yap
Stok Kodu
HTSL1
Kategori
Marka
Havale
3.146,40 TL
(%5,00 havale indirimi)
*
353,45 TL den başlayan taksitlerle!!
3.312,00
TL
KDV DAHİL
Hytech Slide mikrobiyolojik analizler için tüm yüzeylerden besiyeri teması ile analizi gerçekleştirebilen bir üründür. Personel, ekipman, katı sıvı tüm yüzeylerden örnek alabilmesi mümkündür.
Hytech Slide Hijyen Kontrol Kitleri, tek bir kit ile iki farklı analizi pratik bir şekilde yapmak üzere tasarlanmıştır. Her türlü yüzey ortamından, katı veya sıvı materyaller rahatlıkla çalışabilirsiniz.
Taşınması kolay, kullanımı pratiktir. Test sonuçlarının değerlendirilmesi için özel bir mikrobiyoloji bilgisi gerektirmeyen bu kit, hijyen kontrolleri, hijyen denetimi ve HACCP uygulamaları için vazgeçilmez bir üründür.
Hytech Slide’ın iki yüzeyine aynı veya farklı besiyerleri dökülebilir. Böylece birden fazla mikroorganizma analizi tek bir kit ile yapılabilir.
Hytech Slide’ın bir kutusunda 10 adet ürün bulunmaktadır. 10 – 25°C sıcaklık arasında ürünlerin saklanması tavsiye edilir.
Her bir Hytech Slide’da 2 adet besiyeri bölgesi bulunur. 2 yüzeyi de 1 cm2’lik 10 adet bölgeye bölünmüştür. Böylece sonuçlar istenirse 10 cm2’de sayı olarak, istenirse yoğunluk şeklinde verilebilir.
Kullanım Alanları
Hytech Slide hijyen kontrolüne ihtiyaç duyulan pek çok sektörde kullanılmaktadır. En yoğun kullanım alanları; gıda, su, ilaç ve kozmetik firmaları olup; sıklıkla gıda reyonlarında, havuz ve kaplıca sularında, yemekhaneler, hastane ve muayenehanelerde kullanılmaktadır.
Personel, alet-ekipman ve yüzey hijyen kontrollerinde vazgeçilmez bir yardımcı olan Hytech Slide ile ürününüze bulaşabilecek mikroorganizmaların kaynaklarını tespit edebilir ve ürünlerinizi mikroorganizma kontaminasyonundan koruyarak, raf ömürlerini uzatabilirsiniz.
Uygulama Şekli
Uygulama için Hytech Slide’ın kapağı çevrilerek açılır ve Hytech Slide tüpten dışarı çıkartılır. Hytech Slide uygulanacağı yüzeye hafifçe bastırılarak temas ettirilir. 90 derece kıvrılabilen yapısı sayesinde, uygulanması zor, eğimli ve dar yüzeylerde bile besiyeri yüzeyle temas eder.
Sıvı örnekler için Hytech Slide’ı sıvıya bir kez daldırıp çıkarmanız yeterli olacaktır. Besiyeri yüzeyiyle temas ettikten sonra tekrar tüpe yerleştirilerek kapağı kapatılır, dik şekilde inkübasyona bırakılır.
İnkübasyon Süresi
Bakteriler için; 37 C’de 24-48 saat, Küf ve Maya için; 25 C’de 72-120 saat etüvde inkübasyona bırakılır. İstediğiniz analize göre inkübasyonu gerekli koşulları sağlayan oda şartlarında yapabilirsiniz.



Uygulama Şekli
Uygulama için Hytech Slide’ın kapağı çevrilerek açılır ve Hytech Slide tüpten dışarı çıkartılır. Hytech Slide uygulanacağı yüzeye hafifçe bastırılarak temas ettirilir. 90 derece kıvrılabilen yapısı sayesinde, uygulanması zor, eğimli ve dar yüzeylerde bile besiyeri yüzeyle temas eder.
Sıvı örnekler için Hytech Slide’ı sıvıya bir kez daldırıp çıkarmanız yeterli olacaktır. Besiyeri yüzeyiyle temas ettikten sonra tekrar tüpe yerleştirilerek kapağı kapatılır, dik şekilde inkübasyona bırakılır.
İnkübasyon Süresi
Bakteriler için; 37 C’de 24-48 saat, Küf ve Maya için; 25 C’de 72-120 saat etüvde inkübasyona bırakılır. İstediğiniz analize göre inkübasyonu gerekli koşulları sağlayan oda şartlarında yapabilirsiniz.